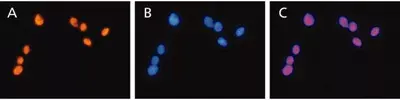
Anti-HMGB2 antibody(AB67282)

Anti-HMGB2 antibody(AB67282)
$undefined

Rabbit Polyclonal HMGB2 antibody. Suitable for ICC, IP, WB and reacts with Rat, Human, Mouse samples. Cited in 32 publications. Immunogen corresponding to Synthetic Peptide within Human HMGB2 aa 150-200 conjugated to Keyhole Limpet Haemocyanin.
| Shipped At Conditions | Blue Ice |
| Appropriate Long term Storage Conditions | Store at -20°C. |
| Clonality | Polyclonal |
| Applications | ICC, IP, WB |
| Species Reactivity | Human, Mouse, Rat |
| Isotype | IgG |